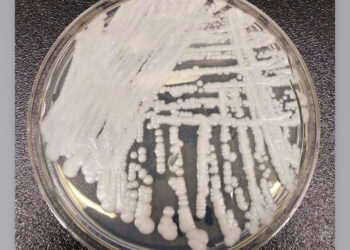
Superfungo: Secretaria de Saúde publica orientações de prevenção após confirmar primeiro caso de Candida auris no RN

Motoristas ficam sem acesso a ganhos após falha em sistema de pagamentos da Uber
27 de abril de 2026
Passageiro morre após acidente em cruzeiro que parou em Natal
27 de abril de 2026
PIS/Pasep: Caixa libera novo lote do dinheiro esquecido nesta segunda
27 de abril de 2026
Exposição Persistir no Instável expõe pesquisa artística na Galeria Conviv’Art
27 de abril de 2026
Semana S inicia contagem regressiva para a segunda edição no RN
27 de abril de 2026


































![[VÍDEO] Motociclista morre após ser atingido por viatura na BR-304 em Mossoró](https://www.jolrn.com.br/wp-content/uploads/2026/04/IMG_6085-360x180.png)